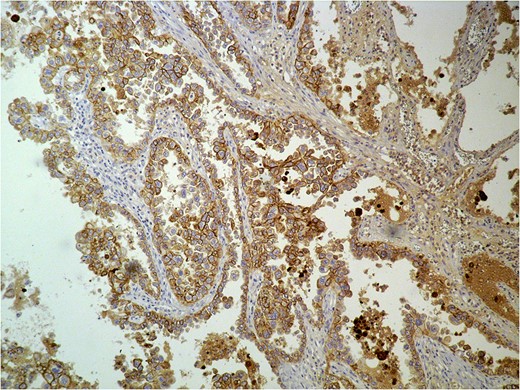
Histologic examination of the excised specimen. Positivity in cytokeratin.

-
PDF
- Split View
-
Views
-
Cite
Cite
Christoforos Efthimiadis, Aristeidis Ioannidis, Konstantinia Kofina, Marios Grigoriou, Primary solitary peritoneal tumor of the abdominal wall—report of a rare case and review of the literature, Journal of Surgical Case Reports, Volume 2017, Issue 6, June 2017, rjx094, https://doi.org/10.1093/jscr/rjx094
- Share Icon Share
Abstract
Abdominal wall tumors are sometimes diagnosed as metastases of ovarian cancer, however, primary peritoneal tumors should be taken into consideration in the final diagnosis. A 49-year-old female patient was admitted in our Department for the excision of a pulpable abdominal wall lump, with no other abnormalities shown on imaging investigation. On histology examination, the excised specimen revealed characteristics of metastatic high-grade serous ovarian carcinoma. Total hysterectomy, bilateral oophorectomy, omentectomy and appendectomy were performed. No signs of malignancy were proved on histology, leading to the final diagnosis of a primary serous peritoneal tumor. This is the third described case of solitary primary serous peritoneal tumor located in the abdominal wall. This condition should be included in the differential diagnosis of a probable metastatic ovarian carcinoma, as both present similar histologic characteristics.
INTRODUCTION
Abdominal wall tumors can present as uncommon conditions, such as leiomyomas, leiomyosarcomas, desmoids tumors or schwannomas; they include more commonly endometriomas or metastatic tumors [1], as due to primary ovarian carcinoma. On the other hand, peritoneal tumors are commonly presented as carcinomatosis with ascites, and only rarely presented as solitary abdominal wall masses [2].
We present the rarest case of an abdominal wall tumor in a woman with free clinical history of gynecologic malignancies, that was initially indicated to be a metastatic mass of high-grade serous ovarian carcinoma, but was later proved to be a primary solitary serous peritoneal tumor.
CASE REPORT
The patient, an otherwise healthy 49-year-old Caucasian female, was admitted to the Surgical Department of our Center complaining about a palpable abdominal wall lump that presented 6 months before, with gradual enlargement and mild tenderness on palpation. Her medical history was free; she had not presented any recent abnormal weight loss, while she mentioned one birth through caesarian section 15 years ago. Her gynecologic history was free and recent routine ultrasonography presented normal findings from the uterus, ovaries and fallopian tubes.
On clinical examination, no specific signs from the abdomen were revealed or any abnormal findings on the site of the Pfannenstiel incision. In the left lower abdominal quadrant, ~3 cm lower than the level of the umbilicus, a solid mass of the abdominal wall was palpated, of a diameter of ~5 cm, with tenderness only on intense palpation.
Complete blood laboratory tests, including tumor markers, showed values within normal limits. An abdominal computerized tomography and magnetic resonance imaging were performed; the latest revealed that the mass presented dimensions of 6.7 × 4.9 × 3.5 cm3, was located on the left rectus abdominis muscle, whereas no further intra-abdominal pathologic conditions were found (Figs 1 and 2). After adequate information and written consent, the patient was submitted to surgical excision of the mass.


Intraoperatively, the mass was found to be in close relation to the uterus, but was excised in healthy borders without the need of hysterectomy. Through direct visualization and thorough examination of the abdominal cavity, no other abnormal conditions or ascites were present, while both ovaries presented normal size. The patient’s post-operative period was uneventful and she was discharged on the third day after the surgery. Histologic examination showed a high-grade carcinoma, presenting high positivity in cytokeratin 7 and CA-125, whereas less in estrogen receptors in immunohistochemistry (Figs 3 and 4), leading to the diagnosis of a high-grade serous carcinoma, that had metastasized from the ovaries.
Histologic examination of the excised specimen. Positivity in cytokeratin.

Histologic examination of the excised specimen. Positivity in cytokeratin and CA-125.
A reoperation was considered necessary some days later, which included total hysterectomy, bilateral salpingo-oophorectomy, omentectomy and appendectomy. No signs of ascites, carcinomatosis, or ovarian abmormalities were present (Figs 5 and 6). Histology of all excised specimens did not reveal any ovarian or other malignancies, leading, thus, to the conclusion that the initial mass was a primary solitary serous peritoneal tumor. The patient was advised to perform a 6-month follow-up control, due to reported poor prognosis of the condition.


DISCUSSION
Peritoneal serous carcinoma is a rare malignancy that is commonly associated with ascites, without significant ovarian involvement, but usually presenting dissemination on diagnosis; however, this did not occur in our case. Moreover, it also affects women of older age (mean age of diagnosis: 57.4 years) and can be related to breast cancer history [3].
Cases of abdominal wall tumors initially diagnosed as metastases of ovarian tumors may basically consist of peritoneal carcinomas. As the mesothelium of the peritoneum and the germinal epithelium of the ovaries share the same embryological origin, primary peritoneal carcinoma can be difficult to distinguish histologically from primary ovarian carcinoma [3]. The morphologic and histological similarities to ovarian serous tumors lead, thus, to difficulties in differential diagnosis [4]. In cases of metastases without detection of a primary site, clinical staging can be difficult; treatment or prognosis cannot be established with precision, either [5]. Conventional imaging methods are not always able to detect primary peritoneal tumors [6], therefore, CA-125 and PET might offer more diagnostic details [7].
Only other two such cases of abdominal masses have been reported in the literature. In the first case, a parietal tumor was found in a 32-year-old woman, with no ovarian or other malignancies, while ascetic fluid was absent [5]. In the second case, a parietal mass of a 60-year-old woman was also diagnosed as an ovarian metastasis after excision biopsy, but radical surgery 5 years later revealed no ovarian pathology [3]. Three cases of Sister Mary Joseph’s nodules that were in fact primary peritoneal tumors have also been described [8].
As these cases are rare, there are not sufficient guidelines considering further treatment or prognosis. Imaging of the chest, abdomen and pelvis, examination of tumor markers (including CA125) and further surgical exploration can help to establish diagnosis and achieve cytoreduction [8]. Adjuvant chemotherapy with platinum/taxane has also been suggested [9]. Primary peritoneal tumors are considered to have a poor prognosis, although in one of the aforementioned cases the patient remained disease-free 1 year postoperatively [3]. In order to achieve an early detection of future pathologies, our patient was referred to the oncologists and was advised to repeat a thorough follow-up control with chest and abdominal CT imaging and tumor markers with intervals of three months postoperatively.
CONCLUSIONS
Primary solitary peritoneal serous tumor of the abdominal wall is an extremely rare entity with unknown prognosis, but with similar histological characteristics to ovarian tumor metastases, presenting, therefore, increased risk of misdiagnosis. High suspicion of this condition in case of parietal masses is important, in order to realize a thorough preoperative examination and improve prognosis.
CONFLICT OF INTEREST STATEMENT
None declared.
REFERENCES
Nath
Kim
Wong
Kim
Matsuura
Chiou
Wang
Popovska
Schickler